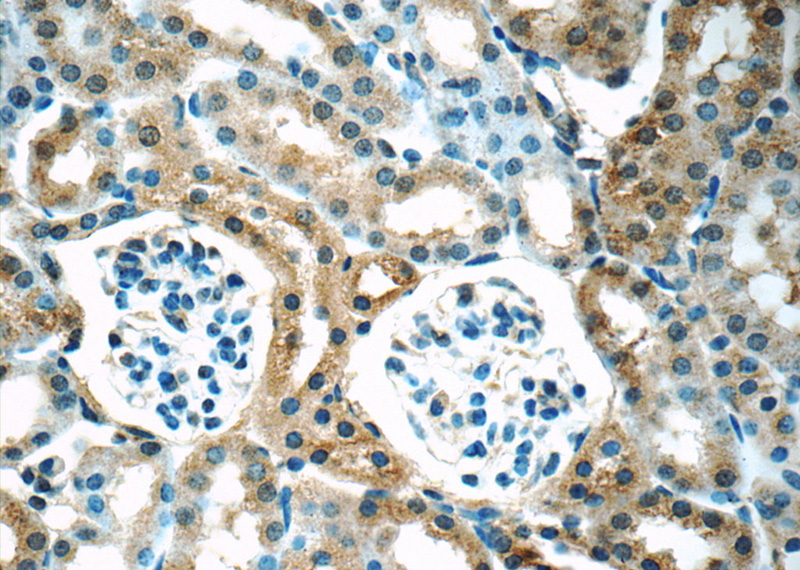
Immunohistochemistry of paraffin-embedded mouse kidney tissue slide using Catalog No:115273(SHH Antibody) at dilution of 1:50 (under 40x lens)

-
Product Name
SHH antibody
- Documents
-
Description
SHH Rabbit Polyclonal antibody. Positive WB detected in mouse liver tissue, rat kidney tissue. Positive IP detected in mouse liver tissue. Positive FC detected in HepG2 cells. Positive IHC detected in mouse kidney tissue, human liver cancer tissue, mouse liver tissue. Positive IF detected in HepG2 cells. Observed molecular weight by Western-blot: 50 kDa
-
Tested applications
ELISA, WB, IF, IHC, IP, FC
-
Species reactivity
Human,Mouse,Rat; other species not tested.
-
Alternative names
HHG 1 antibody; HHG1 antibody; HLP3 antibody; HPE3 antibody; MCOPCB5 antibody; SHH antibody; SMMCI antibody; Sonic hedgehog protein antibody; TPT antibody; TPTPS antibody
-
Isotype
Rabbit IgG
-
Preparation
This antibody was obtained by immunization of Peptide (Accession Number: NM_000193). Purification method: Antigen affinity purified.
-
Clonality
Polyclonal
-
Formulation
PBS with 0.02% sodium azide and 50% glycerol pH 7.3.
-
Storage instructions
Store at -20℃. DO NOT ALIQUOT
-
Applications
Recommended Dilution:
WB: 1:200-1:2000
IP: 1:200-1:2000
IHC: 1:20-1:200
IF: 1:10-1:100
-
Validations

mouse liver tissue were subjected to SDS PAGE followed by western blot with Catalog No:115273(SHH antibody) at dilution of 1:800

Immunofluorescent analysis of HepG2 cells, using SHH antibody Catalog No:115273 at 1:25 dilution and Rhodamine-labeled goat anti-rabbit IgG (red). Blue pseudocolor = DAPI (fluorescent DNA dye).

IP Result of anti-SHH (IP:Catalog No:115273, 4ug; Detection:Catalog No:115273 1:500) with mouse liver tissue lysate 6400ug.
Immunohistochemistry of paraffin-embedded mouse kidney tissue slide using Catalog No:115273(SHH Antibody) at dilution of 1:50 (under 40x lens)

1X10^6 HepG2 cells were stained with 0.2ug SHH antibody (Catalog No:115273, red) and control antibody (blue). Fixed with 4% PFA blocked with 3% BSA (30 min). Alexa Fluor 488-congugated AffiniPure Goat Anti-Rabbit IgG(H+L) with dilution 1:1500.
-
Background
SHH, also named as HHG-1, belongs to the hedgehog family. SHH binds to the patched (PTC) receptor, which functions in association with smoothened (SMO), to activate the transcription of target genes. In the absence of SHH, PTC represses the constitutive signaling activity of SMO. It regulates another target, the gli oncogene. SHH is synthesized as a 45 kDa precursor protein that is cleaved autocatalytically to yield a 20 kDa N-terminal fragment (residues 24-197 in the human gene sequence) that is responsible for all known hedgehog biological activity and a 25 kDa C-terminal fragment that contains the auto-processing machinery(PMID:10753901).
-
References
- Pang P, Shimo T, Takada H. Expression pattern of sonic hedgehog signaling and calcitonin gene-related peptide in the socket healing process after tooth extraction. Biochemical and biophysical research communications. 467(1):21-6. 2015.
Related Products / Services
Please note: All products are "FOR RESEARCH USE ONLY AND ARE NOT INTENDED FOR DIAGNOSTIC OR THERAPEUTIC USE"
